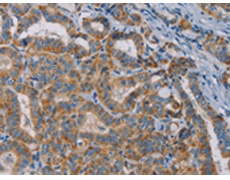
一抗

|
Background: |
The product of this gene functions in the NF-kappaB signal transduction pathway. The encoded protein, and the similar and functionally redundant protein MAP3K7IP2/TAB2, forms a ternary complex with the protein kinase MAP3K7/TAK1 and either TRAF2 or TRAF6 in response to stimulation with the pro-inflammatory cytokines TNF or IL-1. Subsequent MAP3K7/TAK1 kinase activity triggers a signaling cascade leading to activation of the NF-kappaB transcription factor. The human genome contains a related pseudogene. |
|
Applications: |
ELISA, WB, IHC |
|
Name of antibody: |
TAB3 |
|
Immunogen: |
Fusion protein of human TAB3 |
|
Full name: |
TGF-beta activated kinase 1/MAP3K7 binding protein 3 |
|
Synonyms: |
NAP1; MAP3K7IP3 |
|
SwissProt: |
Q8N5C8 |
|
ELISA Recommended dilution: |
2000-10000 |
|
IHC positive control: |
Human thyroid cancer and human brain |
|
IHC Recommend dilution: |
50-200 |
|
WB Predicted band size: |
79 kDa |
|
WB Positive control: |
293T, Raw264.7, NIH/3T3, K562 and Jurkat cells |
|
WB Recommended dilution: |
1000-5000 |


 購物車
購物車 幫助
幫助
 021-54845833/15800441009
021-54845833/15800441009